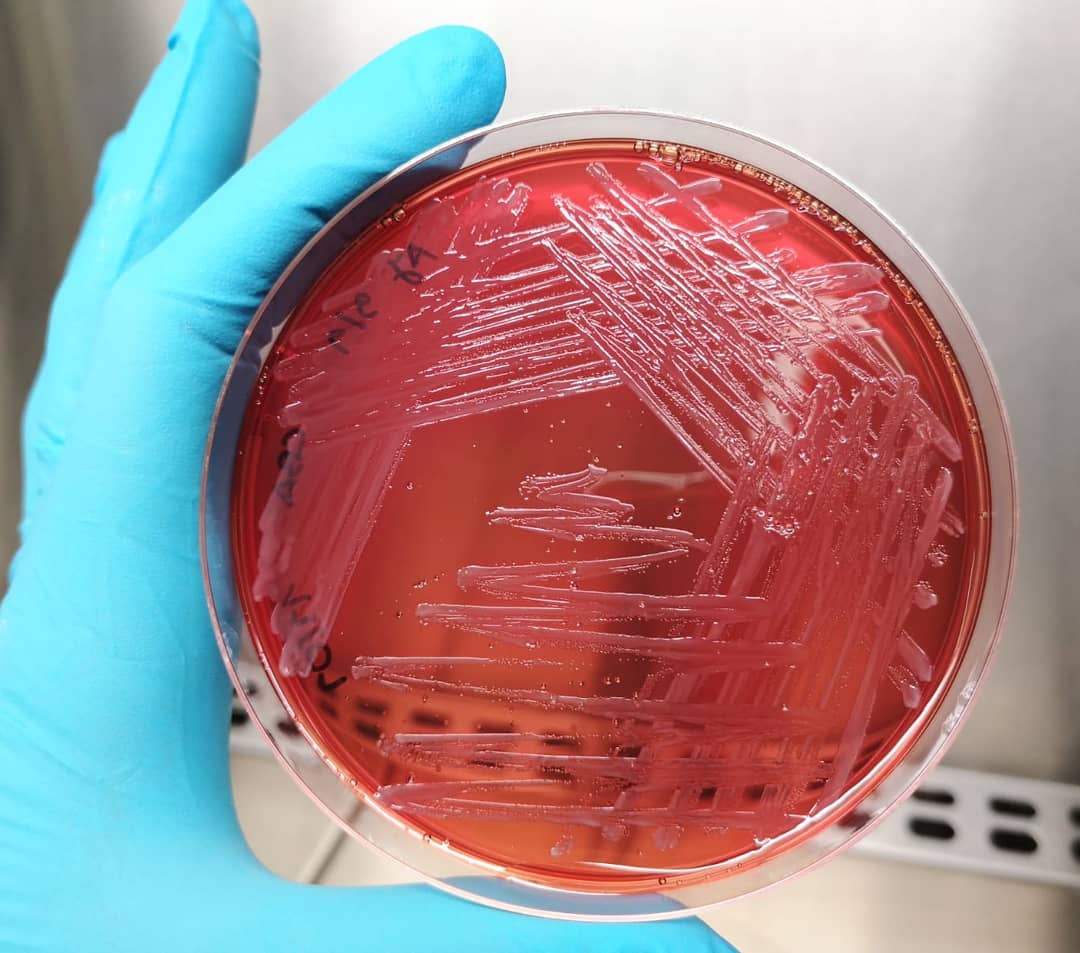
#cutibacteriumacnes is a major colonizer of the human skin causing the  chronic skin disease #acne.
<a href="/projectAMALIA/">AMALIA project</a>  is finding in #seaweeds the potential to tackle this problem!

<a href="/Lemos_lab/">Lemos Lab</a> #COSMETICS #IPLeiria #microbiology

AMALIA project
@projectamalia
Algae-to-MArket Lab IdAas is a EU funded project aiming to develop tools to monitor invasive seaweeds while creating innovative products through biotechnology
ID: 1054859784669806593
http://amaliaproject.eu 23-10-2018 22:19:05
46 Tweet
123 Followers
49 Following


The future is near... #follow EUSEBIO project #bluebiotech #seaweeds #BlueGrowth #BlueEconomy

#Knowledge to #protect! #BlueLabs AMALIA project has a strong focus on young #education. This week we will have multiple activities at the Ocean Open Day with several schools. Today is all about understanding and ID invasive #seaweeds. @EU_EASME EU Maritime & Fish ESTM - POLITÉCNICO DE LEIRIA


#BlueLabs AMALIA project believes that #Knowledge is THE route to #protect #ourocean! Today, at the Ocean Open Day, high-school students are learning about sustainability and #seaweed #biotech potential - hands on style! @EU_EASME EU Maritime & Fish ESTM - POLITÉCNICO DE LEIRIA




🙀 working on further applications for #invasive seaweeds⁉️ Cell culture for #cosmetic and #biomedical devices development 🔎🧪💡 So much potential in #seaweeds... so AMALIA project can't stop having ideas! @EU_EASME EU Maritime & Fish Lemos Lab #bluegrowth #blueeconomy

AMALIA project #Industry Day at Creative Science Park, Ilhavo (Portugal) 28 march Find the potential of #Seaweeds to generate products and contribute to a #BlueEconomy! ALGAplus @EU_EASME EU Maritime & Fish ESTM - POLITÉCNICO DE LEIRIA Universidade de Coimbra Universidade de Vigo @INEGIPORTO Quest Innovation @FollowBIOMIN #ADEPE


AMALIA project #Industry Day at Mercado Progreso Vigo, #Vigo (Portugal) 30 march Find the potential of #Seaweeds to generate products and contribute to a #BlueEconomy! ALGAplus @EU_EASME EU Maritime & Fish ESTM - POLITÉCNICO DE LEIRIA Universidade de Coimbra Universidade de Vigo @INEGIPORTO Quest Innovation @FollowBIOMIN #ADEPE


AMALIA project at PERIN - Portugal in Europe Research and Innovation Network: +Science +Europe meeting. Talk about how this #BlueLab disrupts the paradigm of interaction with #SME, bringing value to a #BlueEconomy. EU Maritime & Fish @EU_EASME Politécnico Leiria Universidade de Coimbra ALGAplus #ADEPE


AMALIA project Industry day and final project session at the Creative Science Park, Ílhavo, Portugal Saturday at Vigo! ESTM - POLITÉCNICO DE LEIRIA Universidade de Coimbra ALGAplus @INEGIPORTO Universidade de Vigo Quest Innovation #ADEPE EU Maritime & Fish @EU_EASME


AMALIA project at Mercado Progreso Vigo (Vigo) ending AMALIA Roadshow, showing products developed and #seaweed potential for the industry... and with a great #showcooking by ALGAplus! EU Maritime & Fish @EU_EASME Universidade de Vigo ESTM - POLITÉCNICO DE LEIRIA Universidade de Coimbra #adepe @FollowBIOMIN @INEGIPORTO Quest Innovation


#Bluelabs AMALIA project keeps its endeavour to promote the use of #seaweeds in the industry 🌊💡🔎🔬🧬🧪🌊 Marta Carmona defended her #MSc on the #biotech potential of Grateloupia turuturu for #cosmetics. Congrats! ESTM - POLITÉCNICO DE LEIRIA Lemos Lab @EU_EASME EU Maritime & Fish #bluegrowth



AMALIA project funded under #EMFF @EU_EASME quoted by Julien Guerrier as a good example of #blue #bioeconomy project. It will produce an edible film for seafood products 🦐🦀🦞🐟 from invasive seaweed. #CircularEconomy #BeatPlasticPollution EU Maritime & Fish Karmenu Vella Victoria Beaz